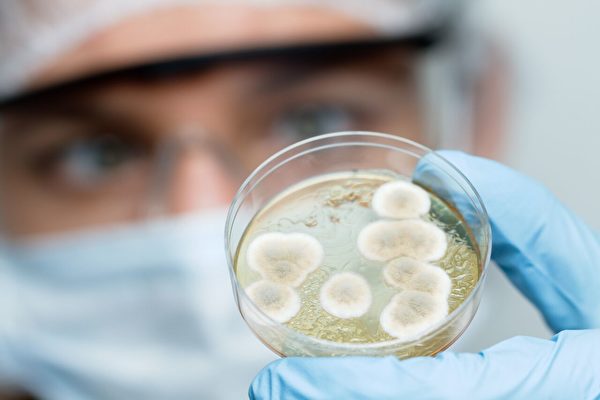

童话故事《白雪公主》里的魔镜,可以回答坏皇后的问题,而现实中的法国,真的有这么一面镜子,但它的作用更加危险,这面魔镜
这个世界500年后会是什么样子?英国、德国和美国的微生物学家为了研究细菌的寿命,开始了一项为期500年的实验。
🔖
宇宙,
dna,
细菌,
细胞,
科学家,
环境,
地球,
微生物,
辐射,
生物学,
古董,
琥珀,

《死海古卷》(Dead Sea
Scrolls)是一套将近有1000份以希伯来文、阿拉姆文、古希
🔖
青铜时代,
耶稣,
石器,
x光,
环境,
圣经,
古董,
古希腊,
铁器时代,
文物,
犹太人,
新石器时代,

无半导体的微电子装置
科学家们已经发明了一种能够释放自由电子的超材料。这种超材料制成的电子器件不需

一份近期重现于世的特斯拉手绘稿揭示了乘数地图,图中阐述简单易上手的数字系统。该手绘稿于亚利桑那州凤凰

阿布希尔阿尔马拉克的警卫查看一座古墓,四周散落着人骨和盗掘洞。盗掘在这里是老问题,但在全球金融危机和2011
🔖
卫星,
柬埔寨,
记忆,
雕像,
古董,
古墓,
浮雕,
眼睛,
古埃及,
文物,
鹭,
棺材,
修复,

我们可凭龟壳区分海龟和陆龟,然而要揭开它们的长寿奥秘,仅观其壳是远远不够的。龟也被称作龟鳖目或龟甲型大盾,凭其颜值即
🔖
进化,
细胞,
科学家,
南极洲,
环境,
地球,
神话,
植物,
长寿,
仙人掌,
化石,
养宠物,
乌龟,
古董,
食物,
海龟,
鳖,
南极,
岩石,

人类战争史的故事性就跟《权力的游戏》一样精彩,甚至更血腥。祖祖辈辈流传下来的智慧只为找出刺伤、致残、射杀的最佳角度
🔖
标本,
科学家,
火箭,
专利,
鸽子,
火箭发射,
雪,
古董,
发明家,
奴隶,
分裂,

这本研究人员称之为“咒术之书”(Handbook of Ritual
Power)的古埃及手册中
🔖
感染,
耶稣,
细菌,
雪,
古董,
古埃及,
疾病,

记者发起了一个项目,咨询全美各大博物馆的馆长,问他们有没有最古怪和最酷的,从来没有拿出来展览过的收藏。结果如何?他
🔖
大脑,
梅毒,
抗生素,
鲸,
标本,
火山,
细胞,
寄生虫,
陨石,
地球,
娃娃鱼,
胚胎,
原子,
青蒿素,
鲨鱼,
植物,
河马,
化石,
生物学,
邪恶,
浣熊,
古董,
琥珀,
眼睛,
鲨,
头骨,
原子弹,
哺乳动物,
熊,
水獭,
细胞分裂,
分裂,

这次的神秘事件要来换换新口味,什么口味呢?就是解得开的口味,因为之前介绍过的神秘事件大多都是无解,害我脑袋一直卡卡,完全

看到木乃伊小编就会联想到神秘或者诡异之类的想法,也正是因为他们身上那些奇异的色彩,总是吸引着人们不段的关注。为何这
🔖
地震,
埃及法老,
木乃伊,
海豹,
细菌,
传说,
科学家,
环境,
地球,
太阳,
墓地,
豹,
雪,
氮,
古董,
古埃及,
疾病,
铁器时代,
头骨,
棺材,
唐氏综合症,
驯鹿,
酒精,
山脉,
岩石,

秦始皇陵一直充满着各种谜团,至今仍有许多无法解开。不过就算不解开也不影响大家对始皇陵的关注和热爱,很多影视剧中都出
